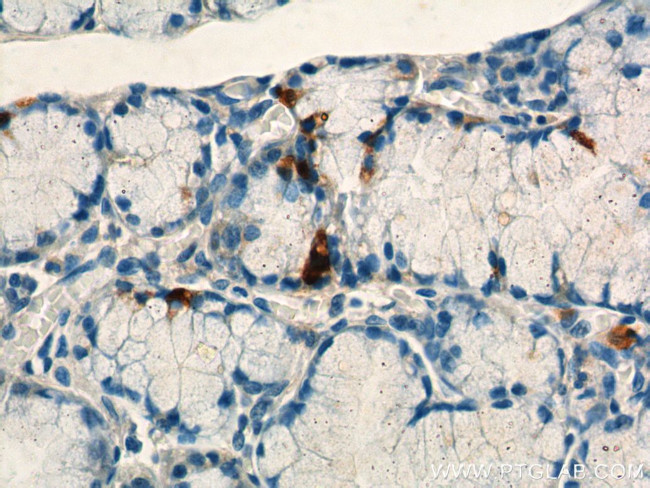
Gastrin Antibody in Immunohistochemistry (Paraffin) (IHC (P))

Search
Proteintech
Gastrin Polyclonal Antibody
{{$productOrderCtrl.translations['antibody.pdp.commerceCard.promotion.promotions']}}
{{$productOrderCtrl.translations['antibody.pdp.commerceCard.promotion.viewpromo']}}
{{$productOrderCtrl.translations['antibody.pdp.commerceCard.promotion.promocode']}}: {{promo.promoCode}} {{promo.promoTitle}} {{promo.promoDescription}}. {{$productOrderCtrl.translations['antibody.pdp.commerceCard.promotion.learnmore']}}
产品信息
18143-1-AP
种属反应
宿主/亚型
分类
类型
抗原
偶联物
形式
浓度
规格
纯化类型
保存液
内含物
保存条件
运输条件
产品详细信息
Immunogen sequence: SEASWKPRS QQPDAPLGTG ANRDLELPWL EQQGPASHHR RQLGPQGPPH LVADPSKKQG PWLEEEEEAY GWMDFGRRSA EDEN (19-101 aa encoded by BC069724)
靶标信息
This antibody may be used to study the differential tissue expression and intracellular and subcellular localization of gastrin in neuroendocrine cells of the gastrointestinal tract, and in the CNS. Antibodies to gastrin are also useful for the identification and detection of gastrin in normal and neoplastic tissue.
仅用于科研。不用于诊断过程。未经明确授权不得转售。
篇参考文献 (0)
生物信息学
蛋白别名: Gastrin; gastrin-1; preprogastrin
基因别名: GAS; GAST
UniProt ID: (Human) P01350
Entrez Gene ID: (Human) 2520